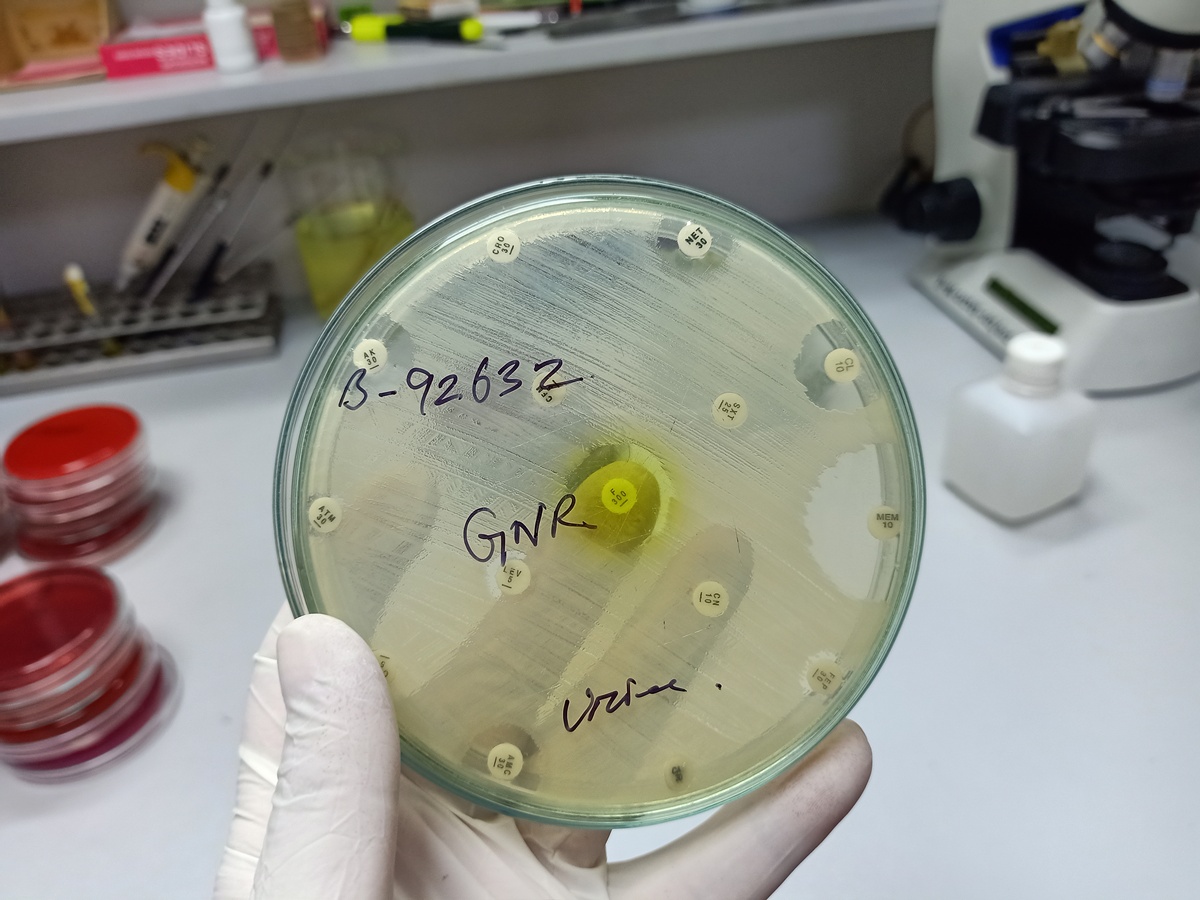
平板菌落集中生长原因分析

平板菌落集中生长原因分析
可能是因为菌落在生长过程中遇到了某种障碍物或者物理条件不利于其均匀分散。例如,可能是培养基的pH值、温度、湿度、营养成分等不够均一,或者培养条件下存在不良的竞争关系,某些菌落生长得比其他菌落快,导致它们聚集在一起。此外,也有可能是实验操作不当,如在接种时将细菌液滴放置在同一位置,或者在培养过程中移动和震动培养皿等原因导致了菌落的集中生长。

原文地址: http://www.cveoy.top/t/topic/oavV 著作权归作者所有。请勿转载和采集!
安全问答是一个知识全球问答,包含丰富的问答知识
可能是因为菌落在生长过程中遇到了某种障碍物或者物理条件不利于其均匀分散。例如,可能是培养基的pH值、温度、湿度、营养成分等不够均一,或者培养条件下存在不良的竞争关系,某些菌落生长得比其他菌落快,导致它们聚集在一起。此外,也有可能是实验操作不当,如在接种时将细菌液滴放置在同一位置,或者在培养过程中移动和震动培养皿等原因导致了菌落的集中生长。
原文地址: http://www.cveoy.top/t/topic/oavV 著作权归作者所有。请勿转载和采集!